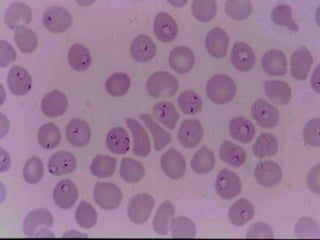

1. Malaria is a major health problem in developing tropical countries, causing hundreds of thousands of cases and deaths annually, with the highest burden in Africa.
2. Plasmodium falciparum is the most common and most dangerous malaria parasite, causing severe complications. Untreated malaria can lead to fever, anaemia, organ dysfunction and death.
3. Malaria diagnosis is by microscopy of blood films or rapid diagnostic tests. Treatment depends on severity, with chloroquine, artemether-lumefantrine, or quinine used for uncomplicated cases and parenteral quinine or artemisinins for severe malaria.